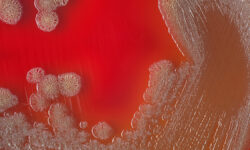
Роспотребнадзор контролирует 321 контакт в Москве после случая холеры у туриста из Индии VibrioCholeraeBacterialColoniesOnBloodAgarPlateAbstractMedical

Правоохранительные органы сообщили о задержании трёх человек, причастных к хищению более 1 млн рублей через программу «Пушкинская карта».
«В ходе расследования установлены и задержаны три фигуранта», — прокомментировали в ведомстве. Им уже предъявлены официальные обвинения.
По данным следствия, злоумышленники организовали покупку 321 билета на культурные события без намерения посещать мероприятия. Это позволило им незаконно изъять свыше миллиона рублей из бюджета и средств банка.
Ранее в СМИ появилась информация о причастности певца Эмиля Кадырова к расследованию. По предварительным сведениям, он совместно с Еленой Гурко, заместителем художественного руководителя зала «Эльдар», проводил фиктивные концерты. Билеты на них массово выкупались через «Пушкинские карты», что стало основой для махинаций.
Следствие продолжает устанавливать все обстоятельства дела и привлекать виновных к ответственности.
Источник: russian.rt.com